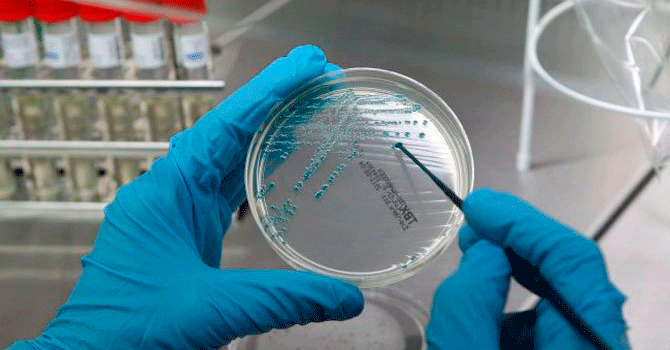

Generalidades
El análisis del ADN (ácido desoxirribonucleico) como molécula que transmite los caracteres por medio de la herencia, ha significado en los últimos años un gran avance tecnológico el cual nos permite entre muchas otras, realizar pruebas de identidad, pruebas de paternidad, pruebas en medicina forense, análisis de ligamiento o parentesco, determinación sexual pre y postnatal, perfil genético, mapeo genético, etc.
Esta prueba es posible realizarla porque en el genoma humano existen secuencias del ADN que se repiten en Tandem y que exhiben suficiente variabilidad entre individuos en una población, esta gran variabilidad alélica es motivo de análisis. Estas regiones del ADN que se repiten en tandem se los clasifica en dos grupos dependiendo de su tamaño. Los VNTRs (variable number of tandem repeats) tienen una secuencia de repetición de entre 9-80 bp, mientras que los STRs (short tandem repeats) contienen secuencias de 2-5 bp.
La comunidad científica que analiza el ADN para uso legal o forense propone primariamente el uso de repeticiones tetranucleótidas STRs, los cuales pueden ser amplificados usando la PCR (polymerase chain reaction) con una gran fidelidad esta amplificación muestra la variabilidad de alelos presentes en una población con el que es posible obtener un alto grado de discriminación entre individuos de una población cuando son examinados múltiples loci de STRs.
El Departamento de Justicia y el Laboratorio Forense de la FBI Norteamericana usa rutinariamente los STRs en muchos casos de identificación humana, tecnología adoptada por otros países desarrollados.
IDENTIGENE-CBBA introduce a Bolivia esta misma tecnología y metodología de avanzada para contribuir a la sociedad y la justicia. No existe un método más exacto que la prueba del ADN, la probabilidad de identificación personal y la probabilidad de identificación de paternidad biológica usualmente es de 99.998 %. IDENTIGENE-CBBA procede con la más alta calidad asegurando un firme y riguroso proceso de prueba, desde la toma de muestras, pruebas por duplicado con controles negativos y positivos, evaluación de los datos, interpretación de los resultados, análisis matemático y conclusiones.
Para una prueba de análisis genético se requiere únicamente una pequeña muestra (0.3 mililitros) de sangre periférico, de fluidos corporales (ej. semen, saliva) o de tejido corporal, también es posible el análisis de muestras secas de sangre y fluidos no degradados. Todas las pruebas son realizadas con la más alta tecnología, profesionalidad y discreción para asegurar la privacidad que merece el caso.